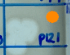

News
Citizen Phage Library publication
20th February 2024

We are thrilled to be co-authors on a recent publication about the Citizen Phage Library (CPL)! We worked with the academic team from the University of Exeter on engaging Citizen Phage Hunters with the project from 2021-2022, and you can find out more on our project resource page. Hopefully this paper will inspire other groups around the world to develop similar programs!
The paper, published in the journal Microorganisms, describes this important work in tackling antibiotic resistance through the power of citizen science. The scientists screened water samples from citizens and wastewater from the Environment Agency with a rapid turnaround. Despite their small lab team, they were able to isolate over 160 potential phages for each strain within five days, sequence an optimised selection within 14 days and select final phages for use in cocktails within 20 days – check out our video lab tour to understand this process.
Antimicrobial resistance is considered as one of the top global public health and development threats, and the work of the CPL could be a really crucial solution. Phages are routinely used in Eastern Europe, and one of the challenges now is to work with regulators and clinicians to get the regulatory framework in place, along with the facilities and safe clinical procedures, so that phages could be used in routine treatments in the UK and Western Europe. The Citizen Phage Library could be an important ‘biobank’ to identify, store and supply phages for patients in the UK, Europe and worldwide – and the CPL team have already supplied phages from the Library to be used in Australia, the US and Canada.
There are now well over 1000 phages in the Citizen Phage Library, and we’re so grateful to all the Citizen Phage Hunters who have contributed so far! We really hope to continue supporting this important project, and fingers crossed the CPL will secure funding to expand their operations.


Phages discovered in the River Exe
As part of the project, Natalie and Alice did some water sampling and found 3 phages in the River Exe by the flood relief channel, Exeter Quay and the Exeter Ship Canal, and these phages are now part of the Citizen Phage Library! They’ve affectionately been named ExeSciCentre, ExeQuayColi, and EXEpedition – and you can see ExeQuayColi doing its thing against E. coli in a petri dish – we are very proud phage parents!